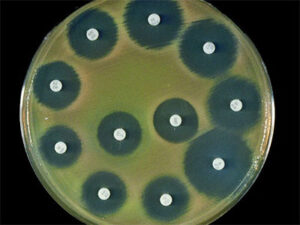

Выявлена новая опасность работы по ночам
Работающие в ночную смену люди чаще других страдают от воспаления кишечника и склонны к набору веса. По данным портала Eurekalert, к такому выводу пришли ученые из Португалии. Исследователи утверждают, что функции группы иммунных клеток ILC3, которые влияют на здоровье кишечника, … Читать далее →